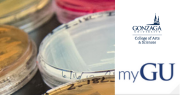
Email Image

Melody Alsaker's Research to Revolutionize Medical Imaging & Save Lives
This year, Melody Alsaker, Alphonse A. & Geraldine F. Arnold Distinguished Professor and associate professor of mathematics at Gonzaga, has been places that would stir awe in her younger self. From organizing a conference session on her research specialty in Tokyo to deeper collaborations between colleagues in Helsinki, Alsaker has set the standard for global scholarship in her field.